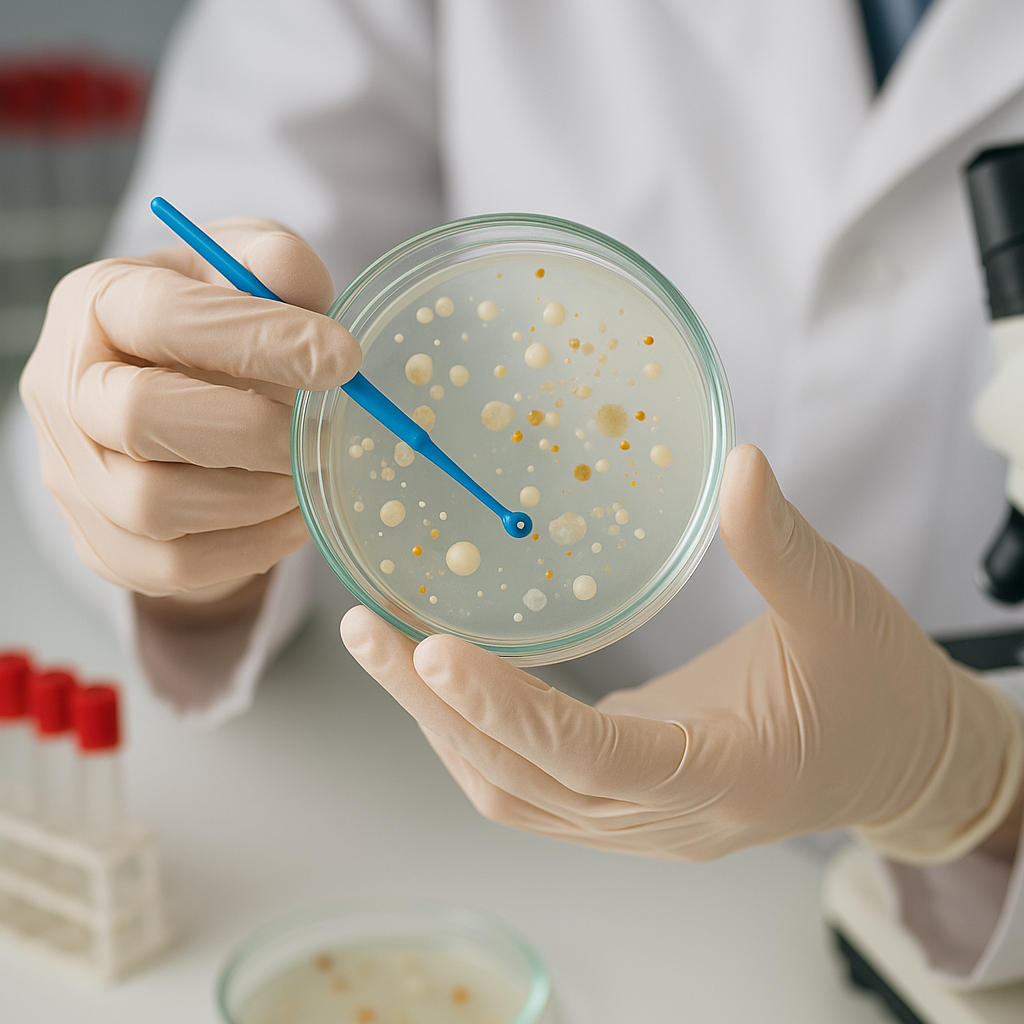

Nova pomada com canabidiol e mupirocina tem ação comprovada contra Staphylococcus aureus resistente e resulta em pedido de patente nacional.
Uma importante pesquisa científica desenvolvida no estado Ceará tem avançado no enfrentamento de um dos grandes desafios da medicina contemporânea: as infecções causadas por bactérias resistentes a antibióticos convencionais. Coordenado pelo Prof. Me. Denis Frota Guimarães, gestor pedagógico do Curso de Medicina da Faculdade 05 de Julho (F5) e docente do curso de Medicina do Centro Universitário INTA (UNINTA) – Campus Itapipoca, o estudo reuniu pesquisadores de instituições dos estados do Ceará e de Pernambuco para desenvolver uma formulação tópica e inovadora à base de canabidiol (CBD) e mupirocina, com potente ação contra Staphylococcus aureus, inclusive cepas resistentes á meticilina (MRSA).
A pesquisa contou com a participação dos professores Dr. Francisco Vassiliepe Souza Arruda, Dr. Tiago Souza de Melo e Dr. Victor Alves Carneiro (UNINTA – NUBEM – LaBAM – UFC Sobral), Rafaela Mesquita Bastos Cavalcante (LaBAM – UFC Sobral) e da Profª Dra. Ana Lucia Figueiredo Porto, pesquisadora do Programa RENORBIO da Universidade Federal Rural de Pernambuco (UFRPE).
A formulação combina dois princípios ativos com mecanismos complementares: a mupirocina, antibiótico tópico que inibe a síntese proteica bacteriana, e o canabidiol, que desestabiliza biofilmes e a membrana celular bacteriana. Veiculada em lanolina anidra, a composição garante alta penetração dérmica e estabilidade farmacotécnica. Ensaios microbiológicos indicaram redução de até 90% da carga bacteriana em culturas de Staphylococcus aureus sensível e resistente, validando o efeito sinérgico da associação.
Patente e novas perspectivas clínicas
Com resultados promissores, a equipe formalizou o registro da invenção no Instituto Nacional da Propriedade Industrial (INPI), sob o número BR 10 2025 009198 4, com o título “Formulação de uma pomada adicionada de canabidiol e mupirocina com ação anti-Staphylocócica”. O pedido de patente foi depositado com a Universidade Federal Rural de Pernambuco (UFRPE) como instituição titular.
A formulação representa um avanço terapêutico com aplicações potenciais em ambientes hospitalares e ambulatoriais, sobretudo em casos de feridas infeccionadas de difícil cicatrização. Segundo o professor Denis Frota, a pesquisa caminha agora para uma nova fase de validação clínica, com testes em pacientes conduzidos em parceria com uma clínica especializada. “Nosso objetivo é fazer a ponte entre ciência e benefício direto à população, com foco na inovação acessível e na melhoria dos cuidados em saúde pública”, afirma o coordenador
Uma rede de ciência aplicada no Nordeste
Os autores estão vinculados a instituições de referência na pesquisa biomédica do Nordeste: Center for Bioprospecting and Applied Molecular Experimentation (NUBEM), Faculdade de Medicina, Centro Universitário INTA – UNINTA, Sobral, CE; Laboratório de Biofilmes e Agentes Antimicrobianos (LaBAM), Faculdade de Medicina, Universidade Federal do Ceará – UFC, Sobral, CE; Programa de Pós-Graduação em Biotecnologia (RENORBIO), Universidade Federal Rural de Pernambuco – UFRPE, Recife, PE
A equipe planeja, ainda, novos estudos farmacocinéticos e clínicos para ampliar as aplicações da formulação, inclusive em feridas crônicas, úlceras diabéticas e infecções secundárias em pós-operatórios ortopédicos, consolidando a proposta como um produto de base biotecnológica com elevado potencial de impacto.